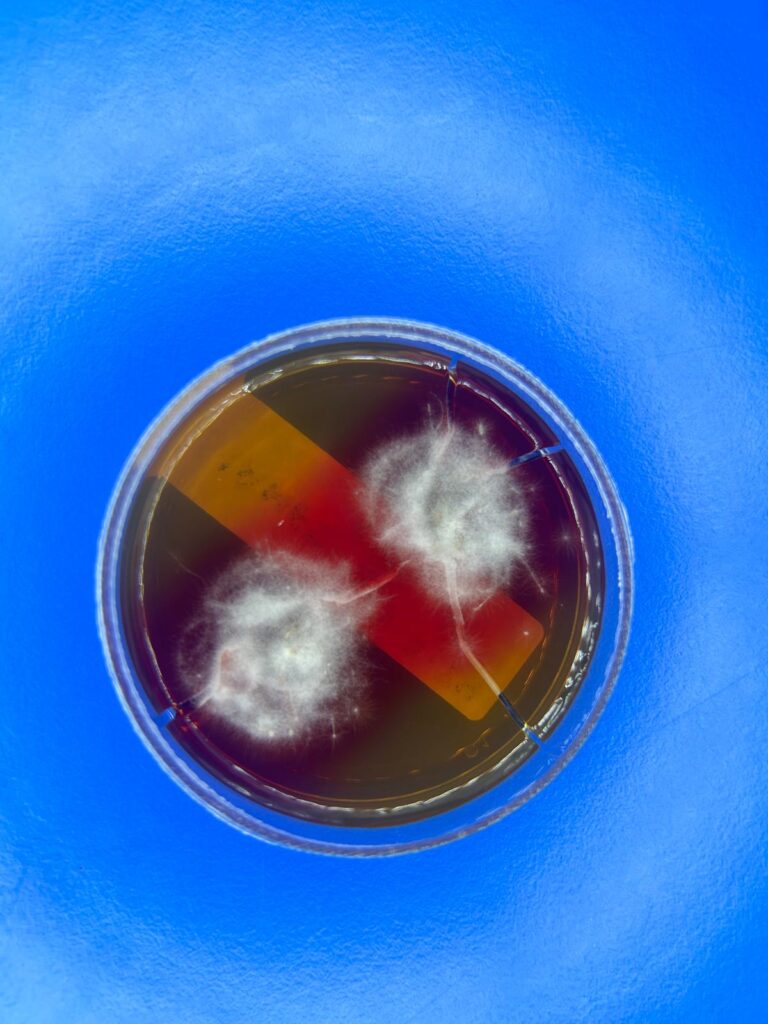
Dermatofitosis o tiña 4 WhatsApp Image 2024 07 11 at 11.14.12 1

La dermatofitosis o más comunmente conocida como tiña, es una infección fúngica que afecta tanto a animales como a humanos (es una zoonosis, y se contagia por el contacto directo entre infectados y sanos, o por objetos infectados). Es muy frecuente encontrarla en los gatos, sobre todo en los que están en la calle, aunque puede afectar a muchas especies, y se propaga muy rápidamente; y es por ello que hoy queremos hablaros de esta patología:
¿Quién la causa la Tiña?
Los hongos dermatofitos son un grupo de hongos capaces de invadir y vivir en tejidos como la piel, el pelo y las uñas, y ellos son los que dan lugar a esta patología.
Síntomas de Tiña
La tiña puede manifestarse de manera diferente en animales y humanos, pero algunos síntomas comunes son:
- En Animales:
- En perros y gatos aparece como áreas de pérdida de pelo, enrojecimiento, lesiones a veces circulares con el filo rojo y el centro blanquecino, picor y descamación en la piel.
- En Humanos:
- Lesiones normalmente de forma circular con aspecto similar a la de los animales. Provoca mucho picor y descamación además de pérdida de pelo.



Diagnóstico de Tiña
El diagnóstico en animales puede ser un desafío debido a la variabilidad de los signos clínicos y la posibilidad de que algunos animales sean asintomáticos. Entre los métodos más comunes y esenciales encontramos:
- Examen Clínico
- Inspección Visual: El veterinario examina el animal en busca de algunos de los signos clínicos característicos previamente nombrados. Las lesiones suelen estar en áreas de piel expuesta y en contacto, como el cuello, el lomo, las orejas, el hocico y las patas.
- Prueba de Wood
- Uso de Lámpara de Wood: Esta prueba utiliza una lámpara especial que emite luz ultravioleta (UV). Algunos dermatofitos, emiten una fluorescencia cuando se exponen a esta luz, Sin embargo, no todos los hongos dermatofitos fluorescen y no todas las lesiones causadas por hongos que sí lo hacen serán positivas.
- Cultivo Micótico
- Cultivo de Muestras: Se toma una muestra de piel,pelo o escamas del animal y se cultiva en medios específicos . El cultivo permite identificar el hongo causante al observar su crecimiento y características específicas bajo condiciones controladas. Este método es el estándar para confirmar la presencia de dermatofitos.

Tratamiento frente a Tiña
El tratamiento de la tiña depende de la gravedad y la localización de la infección:
- En Animales:
- Tratamientos tópicos: En los casos más leves, el uso de champús y ungüentos antimicóticos pueden ser efectivos.
- Tratamientos orales: En casos graves, se puede recurrir a antimicóticos orales bajo la supervisión de un veterinario.
- Desinfección del entorno: Es crucial desinfectar los lugares donde el animal infectado ha estado para evitar la propagación del hongo.
- En Humanos:
- Antimicóticos tópicos: Uso de crema en casos leves según la valoración médica.
- Antimicóticos orales: Para casos más graves o extensos, el tratamiento puede ser sistémico bajo las pautas del médico.

Medidas de Prevención
La prevención de la tiña incluye varias estrategias:
- Cuidado con los animales: Revisar regularmente a las mascotas en busca de signos de tiña y mantener una buena higiene en el hogar. Las mascotas infectadas deben ser tratadas y sus áreas de descanso desinfectadas.
- Ambiente limpio: Desinfectar y limpiar regularmente áreas comunes y objetos que puedan estar contaminados con esporas de hongos.
Por tanto, ante cualquier sospecha de que tu animal tiene alguna patología, lo más importante es ponerlo en manos del veterinario para poder atajarla cuanto antes y que así tampoco suponga riesgos para las personas que convivís con ellos, es por esto que no debes dudar en consultarnos cualquier duda que tengas, ya que contamos con muchísimos servicios para el bienestar de tus mascotas.
Servicios Veterinarios en Gerena – Clínica Veterinaria Razas (razasvet.com)

